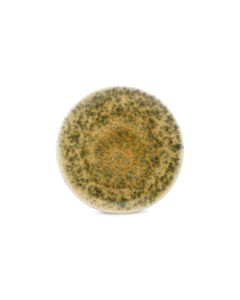

-40%

Assiette creuse 26xH4,5cm vertbrun Resto
Servez avec style grâce à l'assiette creuse de 26 cm vert-brun de la collection Resto. Son émail réactif et sa porcelaine robuste en font le choix idéal pour des soupes copieuses ou des salades colorées. Parfaite pour les bistrots animés, cette assiette allie beauté et praticité avec aisance.
SKU: 743004
8,37 €
13,95 €
(Excl. VAT)
Chargement...
Avec Resto, votre table prend vie !Les couleurs vives rehaussent tous les plats et créent une atmosphère animée en toute occasion. La robustesse de cette collection lui permet de résister à un usage intensif.Lavable au lave-vaisselle, Émail réactif, Porcelaine durable.
| SKU | 743004 |
|---|---|
| Marque | Bonbistro |
| Collection | Resto |
| Type de produit | Assiette Creuse |
| Nouveautés | 3 janv. 2023 |
| Couleur principale | Marron |
| Couleurs | Brun, Vert |
| Matériel principal | Porcelaine |
| Matériaux | Porcelaine |
| Finition | Glacis Réactif |
| Forme | Rond |
| Taille commerciale | 26xH4,5cm |
| Diamètre | 26 |
| Longueur (cm) | 26 |
| Largeur (cm) | 26 |
| Hauteur (cm) | 4.5 |
| Poids | 0,84 |
| Passe au lave-vaisselle | Oui |
| Double paroi | Non |
| Convient pour aliments | Oui |
| Boîte cadeau | Non |
| Caractéristiques artisanales | Non |
| Passe au micro-ondes | Oui |
| Passe au four | Non |
| En matériaux recyclés | Non |
| Unités de commande | 6 |
Inner carton
| Barcode: | 25410595752120 |
| Width: | 0.28 m |
| Height: | 0.11 m |
| Length: | 0.3 m |
| Weight: | 5.04 kg |
| Quantity: | 6 |
Outer carton
| Barcode: | 15410595752123 |
| Width: | 0.325 m |
| Height: | 0.24 m |
| Length: | 0.33 m |
| Weight: | 10.08 kg |
| Quantity: | 12 |
Palet
| Barcode: | 35410595752127 |
| Width: | 0.8 m |
| Height: | 1.1 m |
| Length: | 1.2 m |
| Weight: | 241.92 kg |
| Quantity: | 288 |

Assiette creuse 26xH4,5cm vertbrun Resto
8,37 €
13,95 €
(Excl. VAT)